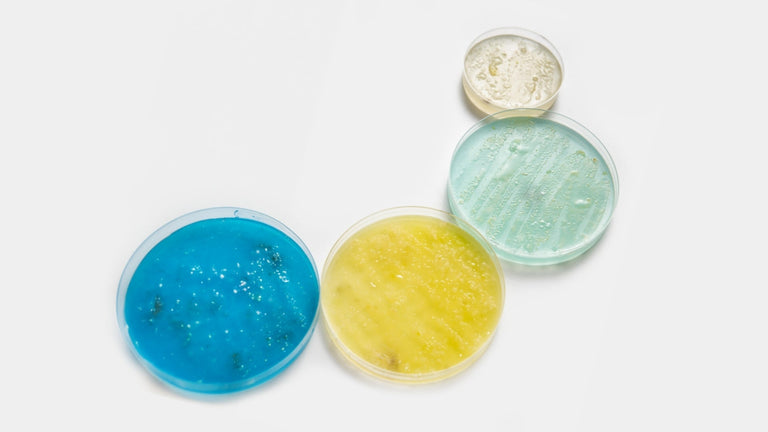

Zima Learning Zone

How Does the Zima Go Lid Work?
July 29, 2024
Oral appliance users will often face challenges when trying to use notoriously unreliable and flimsy plastic storage cases to protect their retainers, aligners, dentures and guards. That’s why we engineered the Zima Go protective case, which works hard to look after both your appliance and your overall oral health. With meaningful design and two years of development, the Zima Go carry case combines form, function and safety into one compact device.

Can I travel with the Dental pod?
July 08, 2024
Maintaining the cleanliness and integrity of your oral appliance is as important when travelling as it is when you’re at home. We are often asked about travelling with the Dental pod, so we’ll outline its pros and cons, and suggest alternative solutions to help you enjoy a hassle-free trip.

Can the Dental pod clean jewellery?
July 04, 2024
While the Dental Pod has been specifically engineered and tested for oral appliances, we have noticed that many of our customers also successfully use their Dental pods to clean jewellery.
The oral microbiome: the gateway to overall health
June 10, 2024
The oral microbiome is an intricate ecosystem of bacteria, fungi, viruses, and other microorganisms in our mouths that plays a vital role in maintaining not just our oral health, but our overall health as well.

How to clean Invisalign aligners? (2025)
June 07, 2024
Invisalign aligners are becoming increasingly popular as a discreet teeth straightening alternative to traditional braces. By incorporating simple yet effective cleaning practices into your daily routine, you can ensure that your Invisalign aligners remain clean, clear, and comfortable.

Zima Dental's Warranty
June 07, 2024
We offer a free 12-month warranty on all our products. Registering your product for warranty coverage only takes a couple of minutes.

How long will my retainers last? (2025)
June 03, 2024
Retainers are essential tools for maintaining the shape of teeth, designed to preserve the results achieved by lengthy (and often expensive) orthodontic treatment. Find out about the importance of looking after your retainers and how to get the most out of your investment for years to come.

Can You Use Denture Cleaner on Retainers?
June 03, 2024
Proper cleaning and maintenance are crucial for keeping retainers free from bacteria and plaque buildup. While denture cleaners are commonly used to clean dentures, many people wonder if they can be used on retainers as well. In this article, we will explore the risks and benefits of using denture cleaner on retainers, alternative cleaning methods, expert recommendations for retainer maintenance, and tips for extending the lifespan of retainers.
Free & Fast EU Shipping
Free of charge on all orders over €35.
Effortless Returns
Order issues? Contact us within 30 days for a full refund
Secure Ordering
We use a secure SSL connection with 256-bit encryption for full safety.